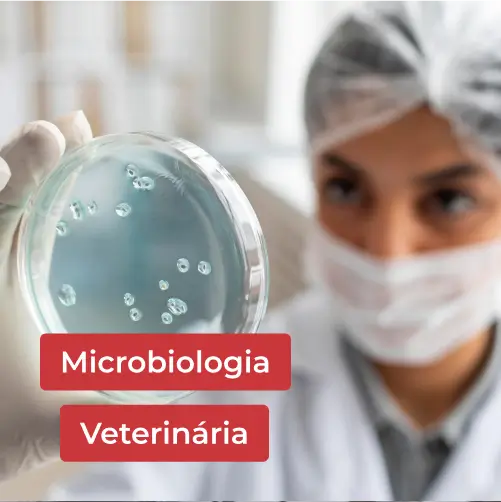

Parasitologia Veterinária
- Descrição
Descrição
SOBRE O CURSO:
Parasitas e hospedeiros. Morfologia dos parasitas. Piolhos e pulgas. Carrapato, ácaros e sarna. Cestoda. Helmintos trematoda. Helmintos nematoides. Protozoários coccídea. Protozoários: piroplasmida e mastigophora. Endo e ectoparasitas. Doença de chagas. Leishmaniose. Toxoplasmose. Hemoparasitismo. Demodicidose. Zoonoses.
OBJETIVO:
Esta disciplina tem por finalidade desenvolver habilidades específicas no estudante do curso de medicina veterinária a respeito da parasitologia animal, visando à promoção da saúde dos animais.
CONTEÚDO PROGRAMÁTICO:
PARASITAS E HOSPEDEIROS EM ANIMAIS
- O QUE SÃO PARASITAS E HOSPEDEIROS NO ÂMBITO DA VETERINÁRIA
- MORFOLOGIA DOS PARASITAS ANIMAIS
- PIOLHOS E PULGAS EM ANIMAIS
- CARRAPATO, ÁCAROS E SARNA EM ANIMAIS
CLASSES PARASITOLÓGICAS ANIMAIS
- CESTODA E SUA AÇÃO EM ANIMAIS
- HELMINTOS TREMATODA E SUA AÇÃO EM ANIMAIS
- HELMINTOS NEMATODOS E SUA AÇÃO EM ANIMAIS
- COCCIDIOSE E SUA AÇÃO EM AVES
PROTOZOÁRIOS, ENDOPARASITAS, CHAGAS E LEPTOSPIROSE EM ANIMAIS
- PROTOZOÁRIOS EM ANIMAIS: PIROPLASMIDA E MASTIGOPHORA
- ENDO E ECTOPARASITAS EM ANIMAIS
- DOENÇA DE CHAGAS EM ANIMAIS
- LEISHMANIOSE EM ANIMAIS
TOXOPLASMOSE, HEMOPARASITISMO, DEMODICIDOSE E ZOONOSES
- TOXOPLASMOSE EM ANIMAIS
- HEMOPARASITISMO EM ANIMAIS
- DEMODICIDOSE
- ZOONOSES
CARGA HORÁRIA: 40h